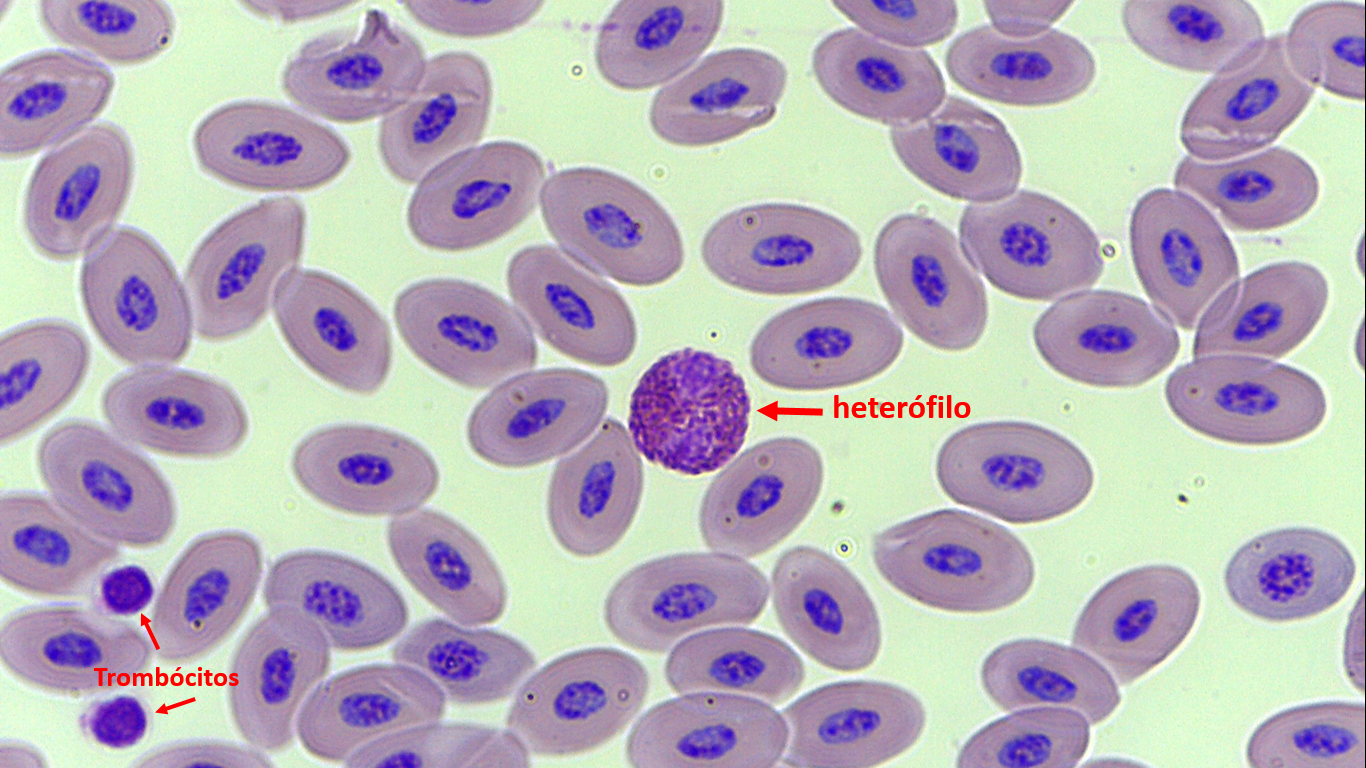
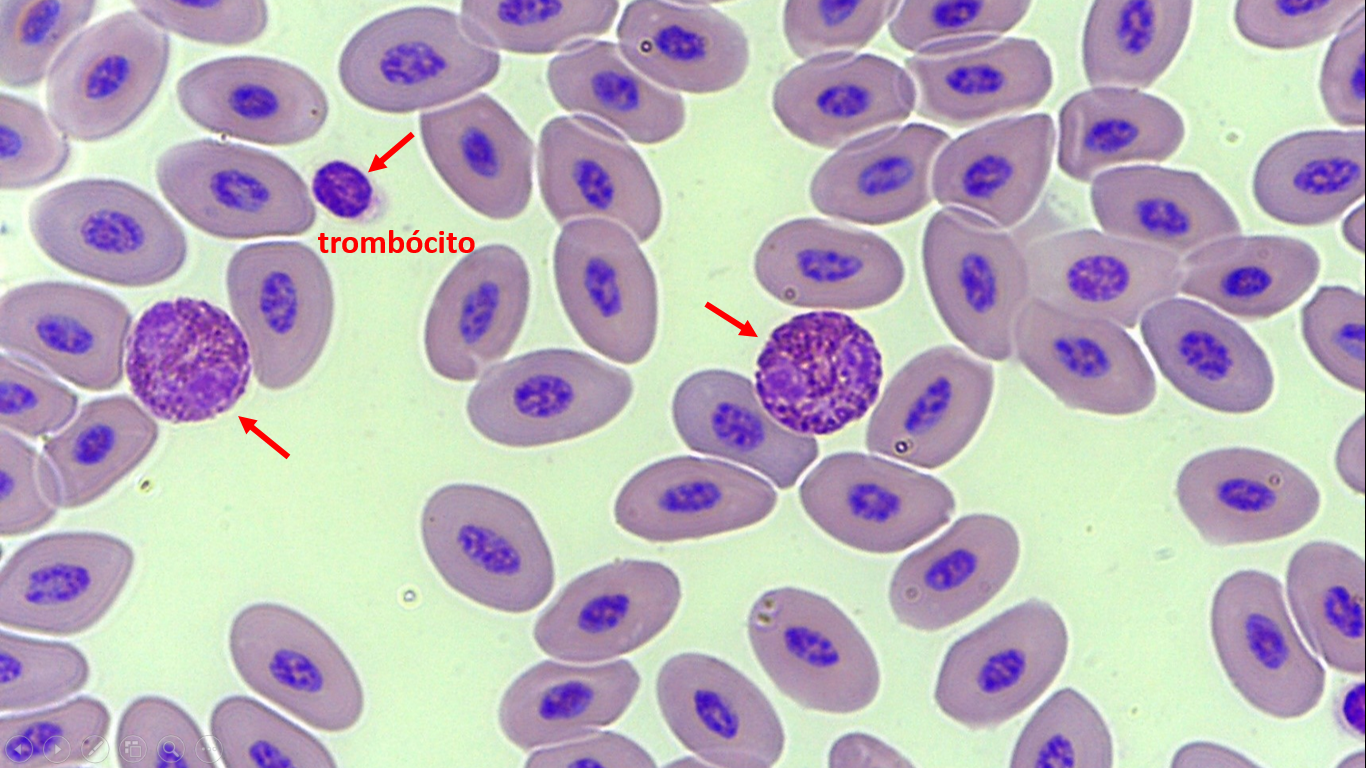
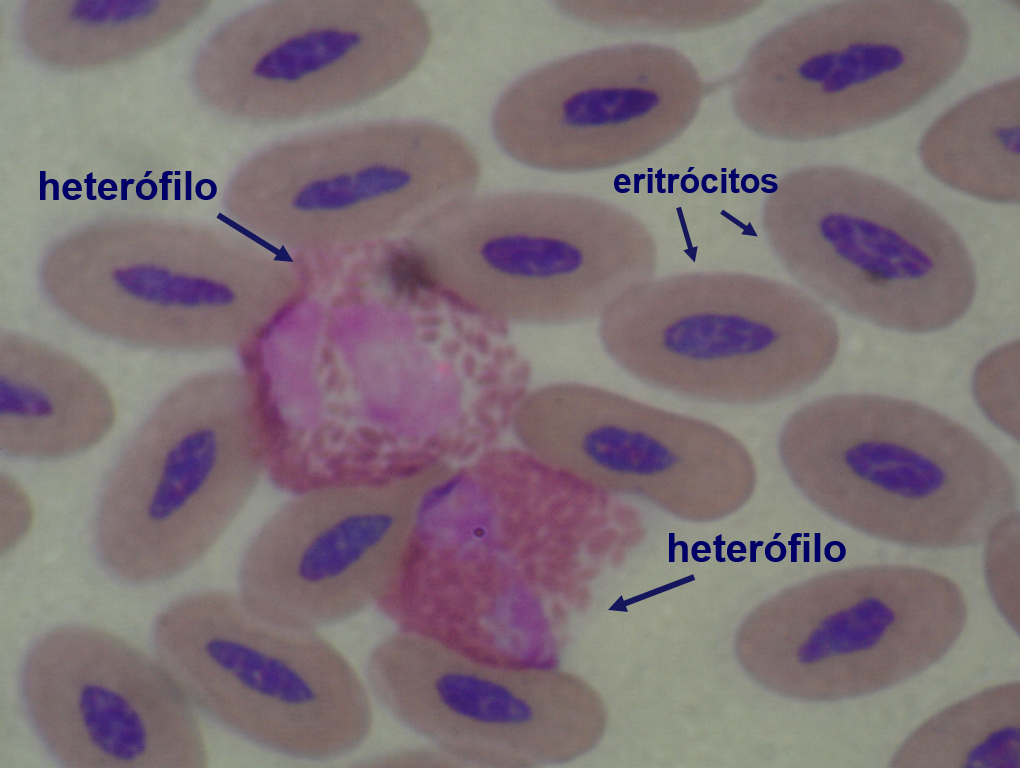

HETERÓFILOS
14)Sangue periférico de pinguim (Spheniscus magellanicus). Eritrócitos maduros, um heterofilo (seta) e dois trombócitos à esquerda (setas). Coloração de Wright (100x).
15)Sangue periférico de pinguim (Spheniscus magellanicus). Eritrócitos maduros, dois heterofilos (setas) e um trombócito (seta). Coloração de Wright (100x).
16)Sangue periférico de cardeal amarelo (Gubernatrix cristata). Eritrócitos maduros e um heterófilo no centro (seta). Coloração de Wright (100x).
17) Sangue periférico de cardeal amarelo (Gubernatrix cristata). Eritrócitos maduros e um heterófilo no centro (seta). Observar grânulos fusiformes do heterofilo. Coloração de Wright (100x).
18) Sangue periférico de jacutinga (Aburria jacutinga). Eritrócitos maduros, um heterofilo no centro (seta), eritrócitos policromatófilos (setas). Coloração de Wright (100 X).
19) Sangue periférico de carcará (Caracara plancus). Eritrócitos maduros, dois heterófilos e um eritrócito policromatófilo à esquerda. Coloração de Wright (100x).
20) Sangue periférico de avestruz (Struthio camelus). Eritrócitos maduros e dois heterófilos. Coloração de Wright (100x).
21) Sangue periférico de papagaio de cara roxa (Amazona brasiliensis) de vida livre. Eritrócitos normais, maduros, três heterófilos bastonetes (com núcleo em bastão, não segmentado). Um linfócito (lado superior direito) e célula rompida (lado esquerdo). Coloração de Wright (100x).
22) Sangue periférico de pavão. Eritrócitos maduros e três heterófilos bastonetes. Coloração de Wright (100x).
23) Sangue periférico de coruja orelhuda (Asio clamator). Eritrócitos maduros, três heterófilos segmentados normais (setas), um monócito (lado inferior direito) e núcleo de célula rompida. Observar os grânulos fusiformes do heterófilo no centro. Coloração de Wright (100 X).
24) Sangue periférico de pavão. Eritrócitos maduros, um heterófilo bastonete e dois heterófilos metamielócitos (núcleo riniforme). Coloração de Wright (100x).
25) Sangue periférico de papagaio. Eritrócitos maduros, um heterofilo bastonete (núcleo não segmentado) e um trombócito. Coloração de Wright (100x).
26) Sangue periférico de pavão. Eritrócitos normais, um heterofilo segmentado e um heterofilo metamielócito (observar a forma do núcleo, riniforme). Coloração de Wright (100x).
27) Sangue periférico de pavão. Eritrócitos normais, um heterófilo mielócito (núcleo oval). Coloração de Wright (100x).
28) Sangue periférico de papagaio. Eritrócitos normais, um heterófilo bastonete e eritrócitos policromatófilos. Coloração de Wright (100x).
29) Sangue periférico de papagaio. Eritrócitos normais, um heterófilo bastonete e um trombócito. Coloração de Wright (100x).
30) Sangue periférico de papagaio. Eritrócitos normais e um heterófilo metamielócito rompido. Observar o núcleo riniforme e os grânulos fusiformes eosinofílicos do metamielócito. Coloração de Wright (100x).
31) Sangue periférico de papagaio. Eritrócitos normais e um heterófilo mielócito (núcleo oval). Coloração de Wright (100x).
32) Sangue periférico de jacutinga (Aburria jacutinga). Eritrócitos normais, um heterófilo segmentado normal à esquerda (grânulos fusiformes) e um heterófilo segmentado “tóxico” à direita (grânulos redondos). Coloração de Wright (100x).
33) Sangue periférico de papagaio. Eritrócitos normais, um heterófilo segmentado tóxico (vacuolização citoplasmática e granulação anormal), um linfócito e um trombócito. Coloração de Wright (100x).
34) Sangue periférico de papagaio de cara roxa (Amazona brasiliensis) de vida livre. Eritrócitos normais, um heterófilo segmentado tóxico (parte superior) com granulação anormal, grânulos redondos. Dois heterófilos bastonetes tóxicos (centro), com granulação anormal. Cromatina de célula rompida (à direita). Coloração de Wright (100x).
35) Sangue periférico de papagaio de cara roxa (Amazona brasiliensis) de vida livre. Eritrócitos normais e um heterófilo segmentado tóxico (com desgranulação parcial). Coloração de Wright (100x).